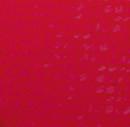

![]()













Professor Thuli Madonsela on how social justice contributes to a sustainable economy
















THE PIVOTAL ROLE OF BLACK-OWNED BUSINESS




The jury is still out on its effectiveness THE GNU










We must be vigilant to not usher in a new leadership deficit

Acting President: Lilly Moabi
Managing Director: Monde Ndlovu
BMF editorial committee: Thulisile Buthelezi, Siphe Zenani and Papama Mnqandi (Chairperson)
Head of communications, marketing and events: Khulukazi Mtebele
Address: The Eric Mafuna House, 12 Summer Street, Rivonia, Sandton, Gauteng, 2196 www.bmfonline.co.za
PUBLISHED BY
Picasso Headline, a proud division of Arena Holdings (Pty) Ltd Hill on Empire, 16 Empire Road (cnr Hillside Road), Parktown, Johannesburg, 2193
Postal Address: PO Box 12500, Mill Street, Cape Town, 8010
VAT Number: 4730261205
Contact Person: Lodewyk van der Walt Tel: +27 21 469 2400 | Fax: +27 86 682 2926 www.businessmediamags.co.za
EDITORIAL
Content Manager: Raina Julies rainaj@picasso.co.za
Contributors: Trevor Crighton, Ryland Fisher, Mwangi Githahu, Dr Shevonne Henry, Chuma Konyana, Busani Moyo, Lerato Nage, Edwin Naidu, Thando Pato
Copy Editor: Brenda Bryden
Content Co-ordinator: Natasha Maneveldt
Online Editor: Stacey Visser vissers@businessmediamags.co.za
DESIGN
Head of Design: Jayne Macé-Ferguson
Senior Designer: Mfundo Archie Ndzo
Cover Image: Supplied
SALES
Project Manager: Jerome van der Merwe jeromem@picasso.co.za Tel: +27 21 469 2484 | 082 668 1496
Sales: Natasha Hendricks, Frank Simons
PRODUCTION
Production Editor: Shamiela Brenner
Advertising Co-ordinator: Shamiela Brenner
Subscriptions and Distribution:
Fatima Dramat | fatimad@picasso.co.za
Printer: CTP Printers, Cape Town
MANAGEMENT
Management Accountant: Deidre Musha
Business Manager: Lodewyk van der Walt
General Manager, Magazines: Jocelyne Bayer
South Africa needs a new lexicon and teleology after 29 May 2024. Over the past 15 years, there has been a continuous decline in the state’s commitment to empowerment and development and an absence of political will to demonstrate intentionality around driving transformation and redress. What often stands out is how we exercise thought, word and deed.
As South Africa’s post-94 political economy was instantaneously catapulted into what is now labelled a government of national unity or GNU, it becomes essential to use our critical and intellectual faculties to mark this seismic paradigm shift. Leaders across all spheres of society, ordinary South Africans, entrepreneurs and professionals must recognise the GNU as a period where they must agitate to ensure the ideal of a transformed South Africa is an outcome of true participatory democracy and justice.
This means there’s a heightened sense of responsibility on each of us rather
4 THE PRESIDENT’S NOTE
Unpacking the pivotal role of black organisations in South Africa’s government of national unity.
5 THE MD’S NOTE
We have shown great promise as a country, but we can aim higher by driving equity within the country and achieve a globally competitive world-class economy.
8 IN CONVERSATION WITH
Professor Thuli Madonsela shares her views around social justice, the economy and leadership.
11 THE BASOTHO HAT MODEL
Has the model inspired a change for an environment that produces fertile soil for aspirant and emerging black leadership excellence?
12 THE LANGUAGE OF EMPOWERMENT
Copyright: Picasso Headline. No portion of this magazine may be reproduced in any form without written consent of the publisher. The publisher is not responsible for unsolicited material. African Leader is published by Picasso Headline. The opinions expressed are not necessarily those of Picasso Headline. All advertisements/advertorials have been paid for and therefore do not carry any endorsement by the publisher.
Has the language of diversity, equity and inclusion impacted a robust struggle for real empowerment and transformation?
14 WOMEN IN LEADERSHIP
Female CEOs share how they are helping cultivate the next generation of game-changers.
than relying mindlessly on the whim of the economic and political elite – conduct that led us to the prevailing socioeconomic context 30 years after 1994.
With this edition of African Leader, we aim to gear up for the impending national dialogue and zoom in on those important matters that must nd expression in that inclusive national agenda. This means we must review our diction and thought paradigms and challenge doctrine. Our choice of words in the terrain of ideas must be informed by true consciousness. Words need not be ideological trappings that keep our state, professionals and entrepreneurs mis ring.
A new vocabulary that puts the need to intensify transformation, empowerment and development front of mind is needed. We must be present and vocal in a national dialogue to restore these to the agenda of government and all social partners.
Papama Mnqandi
Chair of
the BMF editorial committee
18 WHO GIVES POWER TO THE GNU?
The GNU marks a major paradigm shift and the jury is still out on whether this shift is what’s best for South Africa’s future.
20 A NEW VISION FOR ECONOMIC TRANSFORMATION
Regardless of who sits in the national political ruling seat, the BMF is primarily concerned about ensuring transformation in the economy.
21 BLACK-OWNED ENTERPRISES
Black-owned business stands at a critical juncture poised to capitalise on emerging sectors that promise robust growth.
22 THE TRANSPORT SECTOR
The Economic Regulation of Transport Act may nally shake South Africa’s transport sector out of its stupor.
25 BLACK ECONOMIC EMPOWERMENT
Have South Africa’s BEE deals yielded real transformational mergers and acquistions?
26 AFRICAN REGIONAL INTEGRATION
We take a deep dive into the state of African regional integration and learn how it has taken a backseat in the recent past.
28 BMF EVENTS
A roundup of engagements from June to September 2024.
LILLY MOABI, acting president of the Black Management Forum, highlights the pivotal role black organisations must play within South Africa’s government of national unity, emphasising the Black Management Forum’s continued commitment to ethical leadership, transformation and fostering partnerships that drive national growth and accountability
With the Black Management Forum (BMF) preparing to elect a new president in November, we are reminded of the pivotal role the BMF continues to play in shaping South Africa’s leadership and future. This election marks the beginning of a new chapter as the incoming president will lead the organisation for the next three years.
Reflecting on 2024, I am immensely proud of the milestones we’ve reached, particularly the “powerhouse partnership” with Henley Business School. This collaboration reaffirms the relevance and strength of the BMF brand, demonstrating the faith that communities, institutions and members have in our ability to shape the next generation of black leaders. We must revitalise other potential partnerships that have been in the works.
This year, South Africa marked 30 years of democracy – an achievement underscored by progress in electrification, housing, access to running water, and infrastructural development, particularly in rural areas. However, despite these advances, our journey is far from over. With an unacceptably high rate of unemployment and the nation still grappling with one of the world’s highest levels of inequality, as indicated by a Gini coefficient of 0.63, it is clear that systemic challenges remain.
Disillusionment with corruption, maladministration and inefficiency has led South Africans to demand change. This year’s national elections produced no outright majority winner, resulting in a government of national unity (GNU) formed out of citizens’ frustrations with poor governance and their desire for transparent, accountable and visionary leadership.
The original GNU of 1994 aimed to promote nation-building and inclusivity during political transition. Today’s 2024 GNU shares similar objectives, advocating for transformation, inclusivity and national unity. It has rekindled hope that this government model could steer the country toward growth and accountability. As Dr Jakkie Cilliers of the Institute for Security Studies notes: “South Africa needs accountable and competent leadership pursuing evidence-based policies that will allow the economy to create jobs and eventually reduce inequality.” He also highlights that state institutions are hamstrung by deficits in competency, skills, and ethics. This is where the BMF’s role becomes critical.

The BMF has long championed the cause of competent, ethical and skilled black professionals, ensuring they occupy positions of influence and leadership.
The BMF’s involvement in the GNU is crucial, not just in drafting better policies, but also driving policy implementation that tangibly improves the lives of all South Africans.
As architects of the Employment Equity (EE) and Broad-Based Black Economic Empowerment (B-BBEE) Acts, the BMF understands that black professionals are equipped to implement the evidence-based policies South Africa urgently needs. Moreover, the BMF’s involvement in the GNU is crucial, not just in drafting better policies, but also driving policy implementation that tangibly improves the lives of all South Africans.
Reducing unemployment and inequality requires inclusive economic growth. To achieve this, partnerships between the government and the private sector must be fostered. The BMF’s collaboration with Henley Business School Africa serves as an example of the types of partnerships government should support. As BMF managing director Monde Ndlovu points out, the BMF’s legacy of advocating for black leadership and economic inclusion, coupled with Henley’s commitment to developing transformational African leaders, will shape the future of leadership in South Africa. Including the BMF in the GNU will ensure that the right leaders are placed in key positions, allowing the country to implement its progressive policies fully and perform at its best.
The BMF remains steadfast in its commitment to transformation, inclusivity and developing ethical leadership. Our mission is to build a better South Africa and our role in the GNU will be vital in achieving this. Together, we will continue to drive accountability, foster partnerships and create a future where all South Africans have equal opportunities to thrive. After all, building a better future for our country is what we have always strived for.
MONDE NDLOVU, managing director of the Black Management Forum, highlights South Africa’s transformative journey, emphasising engagement, values, broad-based black economic empowerment and education as essential tools to address poverty, unemployment and inequality
The South African journey towards transformation has had many challenges and successes. Defining the key problems has left many unsure about what is being addressed and what resources are being galvanised to ensure the tenets of our democracy are upheld and that all role players in society are engaged. The need to be and remain engaged has come at the right time in our history, and we must foster deeper understanding and commitment towards remaining engaged.
In my opinion, transformation should be viewed as a multifaced approach with many layers and elements.
First, a society cannot transform or fundamentally change without acknowledging what is not aligned with our collective values. If we indeed value human life and dignity, we cannot then accept that many of our people live on social grants, and we cannot accept that we are the most unequal society in the world. The triple challenges of poverty, unemployment and inequality must be the first problem statement we see and define.
Second, the structure of society, especially its economy, needs more focus because it is the economy that will deal with the triple challenges.
Third, government and business – key stakeholders in society – must lead the charge of fundamentally shifting economic levers that will yield greater results.
Fourth, we need to agree on the tools that must be used to usher in a transformed society.
The tools of transformation therefore can be seen in these three ways, first, values.

In rebuilding our society, we must construct a value system to enhance our humanity and sustain our efforts. Ubuntu, as a cornerstone of this, must be used to build a value system that drives a new society. Simply put, every stakeholder must see people as central to transformation and not profits. We must become a people-centred country – this will drive a new narrative in society and business.
Second, the broad-based black economic empowerment (B-BBEE) framework. These five elements need to be the hallmark of every business, institution and stakeholder. Within this framework are priority elements that link directly to solving the triple challenges of our society. We need to rethink the principles underpinning the codes, we are currently working with outdated principles, such as “once empowered always empowered” and “the flow through”.
The targets of all the elements need a fresh look and be aligned with where
we are going in the next 30 years. We have had some successes, such as the growth of the black middle class due to affirmative action, employment equity and ownership transactions inclusive of employee and community share schemes. The focus in the next 30 years should also include a clear view and plan for enterprise development. Key industries that drive the economy, especially the financial services sector, should lead in developing other adjacent enterprises that are black-owned. This is a discussion that needs to be engaged.
Lastly, education and skills development. Our education system needs a relook, especially aligning demand with supply, aligning key industries driving the economy with our education efforts as a country, and encouraging young people to understand the economy and the key levers.
We cannot leave out the importance of management control in the economy. Whoever controls management controls the economy and decision-making. We must lobby to make management control a top priority in B-BBEE.
We must therefore be engaged with a purpose and a burning desire to solve the triple challenges of poverty, unemployment and inequality. If we are not vigilant, we might usher in a fourth challenge, which could be a leadership deficit.
We have shown great promise as a country, but we can aim higher by driving equity within the country and achieve a globally competitive world-class economy.
A society cannot transform or fundamentally change without acknowledging what is not aligned with our collective values.


The University of Mpumalanga (UMP) is a Comprehensive University which offers a variety of undergraduate and postgraduate studies in the fields of Agriculture, Nature Conservation, Hospitality and Tourism Management, Information Communication Technology, Development Studies, Early Childhood Education, Arts, Administration, and Economics. Qualifications offered range from Higher Certificates to Doctoral Degrees offered on two campuses (Mbombela and Siyabuswa).
UMP was established in 2013 and has experienced rapid and gratifying growth since its establishment. In 2024, UMP has enrolled 10,091 and offers 75 Programmes accredited by the Council on Higher Education. The University celebrated its 10th anniversary in 2023 under the theme: A Decade of Excellence and Creating Opportunities. Outstanding attributions of the University include inter alia its iconic infrastructure, the highly regarded Centre for Entrepreneurship Rapid Incubation, its prominent suite of national and international partnerships in support of both undergraduate education and postgraduate and research, and a unique and recognised approach to Engagement.
The University of Mpumalanga has a comprehensive partnership approach, and focus on mutually beneficial, inclusive collaboration that offer inter alia faculty and staff
exchange, joint research activities and publications, special short-term academic programmes, and short and medium-term research visits for graduate students (Masters’ and Doctoral) and postdoctoral fellows. The University has 71 Partnerships and Collaborations, of which 42 are within international countries, including Europe (15), Southeast Asia (11), Africa (9), America (5) and Australia (2). The seven Institutional Research Themes of the University are addressed with the current suite of partnerships.
Amongst others, the University is a member of the following networks:
• Australia-Africa University Network (AAUN)
• Association of Commonwealth Universities (ACU)
• SA-Sweden University Forum (SASUF)
• Regional University Forum for Capacity Building in Agriculture (RUFORUM).
Teaching and Learning at UMP focusses on the development of its students as independent and critical thinkers with a passion for knowledge and its application. Our approach to teaching is theoretically informed, pedagogically appropriate, and sensitive to diversity in all its forms in the

educational environment. Therefore, continuously developing qualifications and curricula are context responsive.
UMP has been able to attract and retain established academics in various disciplines. Currently 52% of UMP academic staff have Doctoral Degrees (one of the highest in South Africa). First Time Entering students (FTEN) are supported in the transition from school to university by a well-developed Orientation Week and a First Year Experience (FYE) Programme. Ongoing support is provided by peer mentors and tutors. As a result of these interventions, student success is generally high with a pass rate of 85%.
The University seeks to produce quality graduates who are (a) resourceful, responsive, and responsible, (b) innovative and entrepreneurial, (c) confident and effective communicators, (d) ethically and socially aware change agents, (e) adaptable, and (f) have sound disciplinary knowledge. UMP has graduated 6,010 students since its establishment.
UMP conducts research that contributes to local, regional, national, and global sustainability. Focussing on research has placed UMP in an advanced position among the institutions

of higher learning despite it being one of the two new universities established in post-apartheid South Africa. UMP has developed rapidly in terms of research capacity development, research disciplines, national and international research partnerships, and research outputs.
The University’s current research areas of interest include agriculture, biological and environmental sciences, information and communication technology, developmental studies, hospitality management and tourism, and education. Amongst some of the key research highlights since establishment includes the year-on-year increase in external research funding and being awarded the National Research Foundation (NRF) Excelleration Award in 2022 which acknowledges South African research institutions for achieving the most improved research performance.
In 2023 UMP was awarded the NRF CEO’s Special Recognition Award, acknowledging UMP’s continued progress and commitment to excellence in research performance. UMP’s research output increases significantly year-on-year, as well as the number of NRF-rated researchers (a national peer-review mechanism recognising excellence and competitiveness of researchers). With state-of-the-art research infrastructure, and numerous national and international research linkages, the University’s prowess and recognition in the research environment is rapidly growing.

Professor Thuli Madonsela engages with Black Management Forum deputy president Lilly Moabi around social justice, the economy and leadership. By RYLAND FISHER
Professor Thuli Madonsela is South Africa’s former public protector and current Professor of Law and Law Trust Research Chair in Social Justice at Stellenbosch University. She holds important views on issues facing our country, including the economy, leadership and addressing apartheid injustice.
She also has sound advice for the Black Management Forum (BMF), as acting president Lilly Moabi found out when she interviewed Professor Madonsela recently.
Moabi began by asking Professor Madonsela how the pursuit of social justice contributes to the growth and sustainability of the South African economy.
Professor Madonsela acknowledged the work of the BMF and its commitment to social justice. She thanked the BMF for “holding the line for this long and not thinking that it is already Uhuru”.
“A just society embraces the humanity of everyone. A capable economy requires capable people, but if a lot of your people are held back by inequality and discrimination, then you’re not running to full capacity.
“Apartheid held back black people, women and people with disabilities, among others, and deprived South Africa of the opportunity to utilise its natural resources and human capital for sustainable growth. Social justice contributes to a developing and sustainable economy through peace and stability.”
Asked about the barriers that are significant to achieving social justice, especially in the context of economic inequality, Professor Madonsela replied: “The greatest barriers
“A just society embraces the humanity of everyone. A capable economy requires capable people, but if a lot of your people are held back by inequality and discrimination, then you’re not running to full capacity.” – Professor Thuli Madonsela

are structural inequalities. There should be a level playing field, everyone’s potential should be freed and everyone should be enjoying the basic necessity of a decent life.”
Professor Madonsela added that inequality is multidimensional. “The fact that people are unequal in the economy is influenced by the inequalities in education, health, community, infrastructure, culture and the education system. We haven’t moved fast enough to address these dimensions of equality.
“One of the issues we haven’t moved fast enough on is land. People say ‘no land is not important; not everyone is a farmer’. That’s missing the point.
“To get finance for your business, you need collateral. The most important form of collateral is land.
“Poor people have no land even just to build their homes, let alone to let it out so that it becomes a source of income. The multidimensional nature of structural inequality has not been tackled systematically and fast enough.”
Professor Madonsela acknowledged the progress made due to affirmative action and thanked the BMF for the role it has played. However, she said, this is not enough.
“The preferential procurement policy framework and broad-based black economic empowerment legislation are some of the instruments that have been used, but it’s a barrier because it is more trickle down, but not everyone is moving up.
“Through the efforts of af rmative action, the black middle class has been created, but this middle class is burdened because they have to carry their families, therefore you need to build a more bulging middle class.
“Finally, we’ve invested a lot in law as an instrument of social change, which is important, but it’s not everything. We need to invest more in conscious conversations about what happened in the past and how the shadow of the past continues to in uence the present.”
Moabi asked about the role of leadership, especially when putting together business and politics, to address South Africa’s inequalities and gender parity problems.
Professor Madonsela responded that leadership is extremely important in that leaders are the ones determining the policies to advance equality and reduce poverty. “But for leaders to be able to do that job properly, they need to be conscious of what advances equality and what exacerbates inequality.
“Organisations such as the BMF, given what you pioneered in the areas of af rmative action, could also work with us in pioneering anticipatory impact assessments.
“Instead of doing an impact assessment after the harm has been done, before any policy law or programme is allowed we look at if the future we want will unfold with this policy. That also applies now with the country looking for investments.”
Moabi wanted to know how the private sector could be more active in promoting social justice and reducing economic disparities, particularly looking at diversity, equity and inclusion.
Professor Madonsela responded, saying the private sector is critical in promoting diversity, equity and inclusion in the economy and within workspaces.
“Why should the private sector do this? Because, rstly, it is the private sector that called for colonial laws such as the Glen Grey Act of 1894 [which
created the homelands], the 1913 Land Act [which took away land from the majority], and the Job Reservation Act of 1923.
“Business at the time deemed that their needs could be met through creating these racial cleavages and a pyramid economy and, maybe temporarily, that worked.
“But it was shooting ourselves in the foot in the long term because now we have an economy where the majority of the people cannot contribute.
“Ultimately, our Constitution talks about freeing the potential of each person, and that’s not just good for the people to have their potential freed; it’s good for us. From an Ubuntu point of view, we understand the interconnectedness of humanity. Respect your humanity as I expect you to respect mine because I understand we’re interconnected. If I push you down, eventually I’ll go down. If I elevate you, I’m elevating myself.
“As a country, we are stronger against the world when everyone’s potential is freed and everyone is elevated to a level playing eld where everyone is playing.
“Business’ interest here is that elevating everyone means high capacity for the country, but secondly it means stability. In the mining industry, they used to speak about the social licence to operate, which is beyond the licence to operate given by government. It means you must have the buy-in of the community.
“The second reason business must come to the party is to ensure peace and stability. Without peace and stability, the fabric of society is undermined. And when the fabric of society is undermined, the social licence to operate is degraded and so is the rule of law.”
Moabi asked about the role of women in society, especially regarding sharing responsibilities with and empowering others.
Professor Madonsela said it is important to showcase role models that have uplifted you.
“As we rise, we should showcase women such as Charlotte Maxeke [South Africa’s rst black woman
graduate] who believed in lifting as they rose. We speak about the ones who left giant footprints for humanity and who have felt blessed in more ways than simply being the rst, but made life easier for those who came after them by making sure that when they got to the top of the ladder, they didn’t just send back that ladder. They built more ladders and sent those ladders back down.
“There’s an African saying that you can never light somebody’s path without brightening your own. But we need an environment that af rms women.”
Moabi asked Professor Madonsela about the role and relevance of black organisations such as the BMF in today’s political and social environment.
Professor Madonsela congratulated the BMF on its 48th anniversary and said the organisation can play an important role in moving the country towards a more equal and socially just society.
“As the BMF heads towards 50, it should congratulate itself on having been able to withstand the headwinds of life. It says to me that there is a role for the BMF and that there has been integrity.
“While we are still an unequal society, we are more equal than we used to be, and the BMF is one of the change agents that have played an important role in bringing us here.
“The BMF now needs to look at things slightly differently because the BMF focused on management and how to build a black middle class. We now need to look at how we participate in diversifying the economy, democratising the economy and broadening the middle class.
“Our Constitution talks about healing the divisions of the past and establishing a new society based on democratic values, social justice and fundamental human rights, where everyone’s potential is freed and every citizen’s life is improved.
“Even though you guys are in business, you have to start thinking about building a society rather than an economy.”


THE CENTRE ON AFRICAN PHILANTHROPY AND SOCIAL INVESTMENT AT WITS BUSINESS SCHOOL offers transformative courses and essential skills to address social challenges and sustainable development across the continent
The Centre on African Philanthropy (CAPSI) at Wits Business School is structured to promote social change by building a culture of effective giving and corporate social and civic responsibility. It offers postgraduate academic programmes that build skills of future leaders in philanthropy, social investment and related disciplines. Applications for the January 2025 intake for the following courses are still open and close on 30 November 2024.
DIPLOMA COURSES
Postgraduate diploma in Philanthropy and Resource Mobilisation (one year, online, full-time block release, NQF level level 8) – provides a comprehensive overview of the complex world of grant-making and grant-seeking and the thinking that shapes resource mobilisation and donor decision-making. It is designed for public policy officials, senior education officers, officials of advancement units at higher education institutions, managers, grant-makers, fundraisers and consultants in the nonprofit sector, community foundations, corporate social investment/responsibility units and general development practitioners.
For detailed information, visit https://capsi. co.za/pdm-in-philanthropy-andresource-mobilisation/
Master of Management in African Philanthropy (one year full-time, NQF level 9) – is designed for students and professionals wanting to broaden their understanding of the field of philanthropy, especially in the context of Africa’s socioeconomic development, and how to manage or establish philanthropic and social investment institutions.
For detailed information, visit https://capsi.co.za/mm-in-african-philanthropy/
CERTIFICATE
The duration of certificate courses is two months.
Fedha – Introduction to Philanthropy –empowers advocates and participants in philanthropic activities with insights into philanthropy within the African context. For detailed information, visit https://capsi.co.za/ fedha-introduction-to-philanthropy-certificate/ Dhahabu – Advanced Certificate in Philanthropy – explores philanthropy and social investment at an advanced level with practical application of these topics. For detailed information, visit https://capsi.co.za/dhahabu-advancedphilanthropy-certificate/ Almasi – Executive Certificate in Philanthropy – aims to develop an advanced and practical application of philanthropy and social investment. It focuses on critical thinking and analysis of core themes and principles in the practice of philanthropy. For detailed information,visit https://capsi.co.za/almasi-executivephilanthropy-certificate/
The duration of a masterclass is two days. Aimed at individuals wishing to develop expertise and strengthen their knowledge in the field of philanthropy and social investment on the African continent, the duration of each of the following Masterclasses is two days:
• Introduction to African Philanthropy
• Introducing the Community Foundations Model
• The Principles and Fundamentals of Fundraising
• Corporate Social Responsibility and Business in Society
• Finance for Social Enterprises and NGO’s
• Venture Philanthropy
• Liquid Leadership in The 21st Century. For detailed information, please visit https://capsi.co.za/masterclasses/


Caption
The Basotho Hat Model represents a powerful management ideal only if black managers embrace it, writes BUSANI MOYO
The Basotho hat, also known as the mokorotlo, is not just a hat, but also a metaphor for leadership and decision-making in African contexts. Its significance in management draws from its cultural meaning, symbolising unity, leadership and connection to the people. The Basotho Hat Model represents this idea. This model highlights leadership qualities that emphasise unity, inclusivity, resilience and accountability while remaining deeply respectful of the community and cultural contexts where one leads.
Monde Ndlovu, managing director of the Black Management Forum (BMF), says: “The Basotho Hat Model was developed to unlock managerial structures and prepare the environment for new blood in the system.”
We asked Ndlovu and the KPMG board chairperson, Professor Wiseman Nkuhlu, whether this model has impacted black managers in South Africa.
Ndlovu says the Basotho Hat Model “emphasises the need to bring black people into the business and economy through affirmative action. This is a positive process, and it carries with it the Afrocentric perspective on management and leadership.” He adds: “When black people are affirmed more, they shape a new culture within the workplace and transpose the values of Ubuntu and enterprise that are uniquely African.”
Ndlovu quickly adds: “Transformation is also multilayered as it goes beyond bringing in black people and challenges the systems and existing processes created by the previous economic tigers.” He continues: “Apart from seeing black people move into management, we still have a challenge at C-suite level;
both black women and men account for less than 20 per cent in the private sector.” It is on this basis that Ndllovu sees the Basotho Hat Model as “a tool to help us analyse in detail who is in the business, what they do, what they produce, what kind of support they need to succeed and how the business fares on principles of justice”.
The impact of the Basotho Hat Model can be assessed by the degree to which black managers and leaders embrace an Afrocentric leadership style.
Asked whether South Africa has made progress in nurturing an Afrocentric leadership ethos among black managers in South Africa, Professor Nkuhlu threw back the question and said maybe journalists and researchers should be speaking to some prolific black leaders of our time, such as Phutuma Nhleko, a leader, Professor Nkuhulu says, who turned MTN into a giant from nothing, and Sim Tshabalala, the CEO of Standard Bank. If the journalists and researchers rise to the occasion, they could learn from these leaders how they have managed to lead in an Afrocentric way. He says this is important because the “delegitimisation of African values in the eyes of leadership was much more complete in Africa than anywhere else”.
“We have made some progress in bringing black people into management, but remoulding the culture of business in South Africa
remains a tall order,” says Ndlovu responding to the question about the progress made regarding living up to the dictates of the Basotho Hat Model.
He concludes: “Hence the need to control management because it’s there where policy and economic decisions are made, where culture is shaped. Therefore, we must not tire in setting our sights on controlling management because he who controls management runs the economy.”
Professor Wiseman Nkuhlu paid tribute to the late founder of the African Bank, Dr Sam Motsuenyane. He says Dr Motsuenyane’s great legacy lies in his showing us that “as African people, we can independently mobilise our resources and create major economic entities of our own”.
Professor Nkuhlu adds that the fact Dr Motsuenyane successfully mobilised one million rand, at the time when he did, to establish the African Bank “demonstrated that the African people could trust each other to tackle great projects, on condition their leaders act with integrity and humility and, above all, can be trusted to put the interests of the people who elected them above their own”.

“We must not tire in setting our sights on controlling management because he who controls management runs the economy.” – Monde Ndlovu
Has the language of diversity, equity and inclusion impacted a robust struggle for real empowerment and transformation? By MWANGI
GITHAHU
Semantic changes in the language of transformation and empowerment by organisations in the business space mean that discussions about diversity, equity and inclusion (DEI) replace the previously militant rhetoric that called a spade a spade.
Organisations, such as the Black Management Forum (BMF), once known for their vocal stance on issues of race and tangible gender empowerment, now adopt terms that argue the same points but may seem somewhat watered down.
Leswene Masekoameng, a social activist and alumnus of the “Africa’s 100 Brightest Young Minds 2022 Cohort,” responds when asked if such organisations have been forced to adopt a softer, more business-friendly language. He claims that this shift is a “tactical” move.
“It is a tactical approach. It is important to engage and interact to find common ground, understanding that business and government are crucial role players in realising transformation, inclusion and diversity,” he explains.
no progress, rather than collaborating to achieve specific goals.”
Masekoameng argues that taking a militant approach towards decision-makers one aims to influence is futile. “You need businesses to provide you with an audience and listen to you. Ultimately, it comes down to the communication and language that role players hear and understand; otherwise, there won’t be a win-win situation.”
Masekoameng believes the language of DEI reflects broader efforts to address the nation’s legacy of apartheid and racial segregation, noting that the BMF gradually aligns with DEI language, even though it hasn’t fully adopted it yet.

He acknowledges that the previous, more direct language used for advocacy has helped achieve specific goals and has fostered better relationships with the BMF, leading to successful contributions to affirmative action, employment equity and other initiatives. However, he refutes the idea that this change in language stems from concerns that the old language of transformation deters foreign and domestic investors.
The publication concludes that “the effect of BEE in companies has been positive and that, when applied, BEE enables inevitable economic growth”.
One criticism of DEI initiatives in South Africa is the potential for tokenism, where organisations may focus on meeting racial or gender quotas without genuinely integrating inclusive practices.
There remains resistance in some sectors to the deep structural changes needed for true equity and inclusion, and some, particularly those who benefitted from apartheid, may feel threatened by these changes.
Professor Ntsikelelo Breakfast, director of the Center for Security, Peace, and Conflict Resolution at Nelson Mandela University, notes that while there have been positive changes, more can be done.

“Adopting a confrontational stance often results in opposing parties making
He points out that the argument claiming transformation scares investors overlooks the Acta Commercii 2014 Journal, which examined the impact of black economic empowerment (BEE) on profit and competitiveness in South Africa.
“It is important to engage and interact to find common ground, understanding that business and government are crucial role players in realising transformation, inclusion and diversity.” – Leswene Masekoameng
“We cannot critique contemporary specificities without invoking the past because the past is still with us. Society is the product of the past,” he says. “History enables us to appreciate what has happened in the past. Now, the problem is that some people don’t want to let go of their privileges. Hence, they don’t embrace transformation and diversity.”
On the issue of developing and implementing racial and gender quotas in the workplace, Professor Breakfast says: “There is resistance because some people think that because they constitute the minority, if they open up to the majority, the majority might assimilate them and they will cease to exist, which is not true. So, we still have that resistance.”

Female CEOs chat with THANDO PATO about how they are helping cultivate the next generation of game-changers
Despite the challenges women in corporate South Africa face, there have never been as many women in leadership positions as there are currently.
Data from the latest SNG Grant Thornton Women in Business 2024 report shows a 9 per cent increase in female CEOs in 2024, rising from 30 to 39 per cent. While female empowerment can be attributed to various external factors, such as legislation and diversity and inclusion programmes, women leaders advocating for other women is also a factor. So, how are women in leadership paving the way for the next generation of game-changers?
Felicia Msiza, CEO of road and civil engineering contracting firm Raubex, says gender inclusivity is a topic close to her heart. “I will never stop advocating for gender equity and diversity and the need to ensure transformative change in corporate culture. As a female leader, I owe it to future generations of women to be vocal on the topic and to set an example for others to follow.
Patricia Pillay, CEO of Polyco, a nonprofit company that invests in recycling and collection, says her organisation prioritises recruiting black women and has significantly increased their representation from under 20 per cent at junior levels to over 60 per cent across all levels of the business.
In addition, Polyco also prioritises the growth of women in business within communities. “We’ve established an enterprise development department that focuses on empowering women, youth and differently-abled individuals. Additionally, we offer learnerships and training programmes for young women, encouraging them to thrive in what was once a male-dominated industry. We also support female waste reclaimers countrywide by providing hygiene packs, PPE and operational support to help them run their businesses effectively.”

mentees. Most are from Soshanguve, my home township. We focus on a theme each year, and I host them for a day, with subject matter experts invited to address some of the pertinent issues they face,” explains Msiza.
Pillay also advocates mentorship. She says it is a crucial tool young women should use to navigate their careers. “While young women often possess the necessary knowledge and qualifications, they tend to lack some of the foundational skills required to advance in the workplace. Key areas I focus on include networking, effective communication with management, emotional intelligence, professional conduct in board meetings and conflict resolution. These skills are vital for growth and success but are often overlooked, making them significant challenges for many women today,” she explains.
“But I also acknowledge that we are on a journey toward real transformation both at Raubex and in the construction and mining industries, so I will continue voicing my thoughts on empowerment here and in our sector,” she says.
Both Msiza and Pillay are staunch advocates of mentorship. Msiza has, for the last decade, been running a mentorship programme in her personal capacity with women across industries. “It’s been amazing and rewarding to see many of these women go on to qualify, some as chartered accountants. One is a practising industrial psychologist after completing her master’s degree cum laude
“The programme has grown since 2020 thanks to Raubex’s support, and we now have about 40 young female
“I will never stop advocating for gender equity and diversity and the need to ensure transformative change in corporate culture.” – Felicia Msiza
Msiza’s advice to future female leaders is: “Never stop learning. Never turn away an opportunity to develop yourself.” She advises these leaders to constantly ask people for advice and more information and seek mentors with whom they can connect.
Msiza also refers to the importance of learning how the organisations women work for operate, what they do and how they do it. She concludes: “Believe in your abilities but don’t believe in yourself to the point of excluding all others because that, in my honest opinion, is a formula for disaster.”


Diversity, equity and inclusion drive innovation, foster employee success and offer a competitive edge – guiding our impact on communities worldwide, writes CUMMINS INC
Our company thrives when everyone is respected and included, and we remain committed to cultivating a culture where every individual feels they truly belong.
“We are courageous in our commitment and united in a relentless desire to see a world, workplace and culture where all people are embraced for who they are, what they contribute and what they aspire to achieve,” says Jennifer Rumsey, chair and CEO of Cummins Inc.
With nearly 60 000 employees across 59 countries, diversity, equity and inclusion (DEI) has always been at the core of our success. Research consistently shows that diverse and inclusive organisations outperform their counterparts. Inclusive workplaces enhance collaboration across cultures, functions and languages – key to navigating our global and varied customer base. DEI also underpins our role as a responsible corporate citizen, ensuring that our actions reflect our values and generate a positive societal impact.
“We are courageous in our commitment and united in a relentless desire to see a world, workplace and culture where all people are embraced for who they are, what they contribute and what they aspire to achieve.”
– Jennifer Rumsey
Pearl Mashabane, DEI regional leader at Cummins Africa Middle East, exemplifies our commitment to diversity, equity and inclusion.
Born in Limpopo, South Africa, she holds a postgraduate degree in psychology from the University of Pretoria and executive education certifications. Mashabane’s career began in public health, where she worked as a senior counsellor for HIV programmes, later advancing to manager for employee health, wellness and diversity management at the Department of Public Service Administration. There, she also served as a gender advocate.

Our workforce represents a rich spectrum of skills and perspectives, bringing our commitment to “win with the power of difference” to life.
Central to this vision is advancing under-represented groups –especially women – whose contributions are increasingly visible across the business.
Her extensive DEI expertise spans roles in the public sector, financial services, higher education and private consultancy, all before joining Cummins. Influenced by her mother, who instilled principles challenging cultural gender norms, Mashabane’s work reflects her passion for cultural diplomacy, equality and allyship across the Africa Middle East and Central Asia Region.
“All employees are expected to be co-creators of a culture of inclusion, taking collective responsibility for DEI,” says Mashabane.
“I believe in creating opportunities where women can thrive because when they do, businesses and communities flourish,” states Tshepiso Ndlovu.
Ndlovu, a key player in Cummins South Africa, brings extensive industry expertise to her role. A chemical engineering graduate from the University of Johannesburg, she is currently completing a BA in marketing, with a focus on B2B management.

Ndlovu’s career spans over a decade in mining and mineral processing where she has held roles in process design, tendering and account management.
Ndlovu, the Durban branch manager, joined Cummins South Africa as a key account manager, overseeing cross-border dealer networks across Mozambique, Angola and beyond. Ndlovu manages contracts, warranties and annual operating plans with significant budgets, cultivating relationships with industry giants in the mining and industrial sectors.

This customer-centric foundation paved the way for her current role.
Outside of work, Ndlovu, a mother of three, dedicates her time to mentoring young girls and promoting women’s development in business.
Cummins South Africa’s apprenticeship programme, led by Mandy Hunt, showcases our commitment to fostering diversity and developing future talent. This programme not only prepares women for technical careers, but also serves as a model for corporate investment in skills development –benefitting individuals and driving economic growth.
The programme offers a blend of classroom-based learning and hands-on training, equipping apprentices with technical expertise and essential “soft skills” such as teamwork and interview techniques.
“We go beyond simply caring for their wellbeing,” Hunt explains. “We empower apprentices through personal development, offering one-on-one coaching and career mapping to help them achieve their goals within Cummins.”
Cummins Inc. is a global leader in power solutions, with a legacy of innovation and reliability since 1919. Headquartered in Columbus, Indiana, the company designs, manufactures and services a diverse portfolio of products, powering industries worldwide.
At its core, Cummins represents dependability, sustainability and advanced technology. Through initiatives, such as Destination Zero, Cummins pioneers solutions to global challenges, including the transition to zero-emissions technology. With a presence in nearly every corner of the globe, Cummins continues to harness collaboration, research and innovation – meeting today’s needs while building a sustainable future for generations to come.

One success story is Nelisiwe Kabini, now branch manager at Cummins in Middelburg. Kabini joined in 2014 as an apprentice at the Master Rebuild Centre in Johannesburg, where she focused on product training and qualified as a diesel fitter by 2016. Today, as branch manager, she leads a team responsible for equipment repairs, ensuring high standards of customer service, and on-site technicians mostly posted at mine sites, and balances management with client engagement.
“We empower apprentices through personal development, offering one-on-one coaching and career mapping to help them achieve their goals within Cummins.” – Mandy Hunt
“It’s challenging because I interact with employees and customers, working with a broad team,” says Kabini. While she has achieved notable success, she acknowledges that biases remain in a male-dominated industry.
“Despite Cummins having the right policies and procedures, we still encounter gender stereotyping in the market, particularly the view that women cannot succeed in demanding industries such as mining. “I had to overcome external doubts and my own insecurities, proving to myself and others that I am capable. I’ve had to work twice as hard to earn my place, and I’m proud of what I’ve achieved,” Kabini concludes.
Cummins’ unwavering commitment to diversity, equity and inclusion shapes not only our workplace, but also society at large. By investing in women’s development and fostering diverse talent, we build a culture where everyone has the opportunity to thrive. Through leaders like Mashabane and success stories such as those of Kabini and Ndlovu, we underpin that DEI is not just a corporate responsibility; it’s a business imperative that drives growth, innovation and meaningful change.





For more information www.cummins.com
DR SHEVONNE HENRY, the chair of the Black Management Forum policy and research committee and PAPAMA MNQANDI, chair of the Black Management Forum editorial committee, unpack the pivotal shift following this year’s national elections. They share that the formation of the government of national unity has triggered debates on transformation, political will and participatory democracy

Among various groupings of professionals, businesspersons and certainly in the Black Management Forum (BMF), there is consensus that none imagined, despite wide analysis and predictions, that our cabinet and parliament would look the way it does today.
Our government of national unity (GNU) marks a major paradigm shift to the South Africa as we have known it for three decades, with serious implications for governance and power. The jury is out on whether the GNU outcome is what’s best for South Africa’s future, despite all the fanfare energising social media with every episode of our new cabinet ministers.
Opinion swings continuously with some sectors of our society still sceptical and others even going as far as proclaiming the GNU is the best thing that has happened to South Africa. Indeed, professionals in South Africa have found some of our leaders to be quite aloof, inaccessible, tone-deaf and unable to read the room.

The wholesale changes we have therefore seen in cabinet, parliament and parliamentary committees are in many ways welcomed, mainly because there is an expectation that leaders will do things differently. While the growing level of interaction between some of the new ministers and the public through social media has become an instant hit, we who have a responsibility to be more thorough in critique remain dissatisfied.
We have opted to look at the GNU Statement of Intent issued on 14 June 2024. This is informing some of the member initiatives within the BMF and has led to the Young Professionals hosting a series of sessions aimed at collecting ideas to contribute to the national dialogue that has been touted since the advent of the GNU.
It is quite evident that since the call for the dialogue was made, there is not much dialogue underway to model it or prepare for it. The citizenry is seemingly awaiting the same voices who have called for it to also begin the talks. And so we are grappling with how to make it clear to many South Africans, beyond professionals and entrepreneurs who are BMF members, that the national dialogue is ours, intended to be for us by us.
The moment calls for meaningful and inclusive engagement and a consciousness that will inform real participatory democracy practises. Strangely, even civil society seems to be waiting for permission to commence this national dialogue and its meta-dialogues that should be the hallmarks of a healthy and vibrant democracy.
The GNU as an outcome of lower voter turnout to the 29 May election and rising apathy signals the citizenry’s profound disappointment
It is quite evident that since the call for the dialogue was made, there is not much dialogue underway to model it or prepare for it.
with the slow pace of socioeconomic transformation. The GNU moment therefore coincides with a period in the evolution of our democracy when South Africans will tolerate nothing less than real change. This requires political will to bring about radical social transformation to address the triple burden of poverty, unemployment and inequality.
Furthermore, the people need to see that political will translated into a consolidated and cohesive plan of action supported and implemented by all spheres of government, industry and civil society. The Statement of Intent is not one such action plan, but contains a set of ideas that set the scene for the prospects of developing one through people engagement.
While we at BMF remain committed to constitution-driven social transformation, we must equally guard against the same constitution being used to dehistoricise inequality and create a context where the deinstitutionalisation of poverty, inequality and social justice is dependent on the status quo.
In the South Africa of today, social transformation as an imperative continues to be held ransom by the interests of a minority population who see the marginalised as a burden to the taxpayer. They also fail to acknowledge the historical and intergenerational impact of structured and systematic oppressions of colonialism and apartheid and the need for a concerted collective effort to redress these injustices.
What would be striking though is if the last 30 years saw the same challenges despite a cabinet, parliament and
portfolio committees being led by a 10-majority political elite with lots of development plans. It must concern us and ignite active citizenry participation that we are now governed under a collective of complex and convoluted interests.
So far we are witnessing the various power plays and trade-offs between political interests while we look on from the gallery. The GNU period in its storming period will likely be more about our cabinet members finding each other and jostling for power in the short term with little focus on transforming the lives of South Africans.
Phrases like “let us follow the money” and hosts of reviews underway by portfolio committees suggest that many who have found themselves in parliament are likely to spend the time reviewing 30 years of the democratic order and, at best, positing themselves as the revisionists of post-1994 South Africa. Very little is seen or heard by the public about actual meaningful transformation that will focus on developing and empowering the people and stop the South African state and economy from misfiring.
Much work is needed to ensure the state is an employer of first choice for the careers of our professionals who need protection from political interference and nefarious interests. As a result, our state has been a kind of Hollywood, full of acting director generals, heads of department and managers with plenty of positions remaining vacant despite a high rate of unemployed graduates.
It has therefore been encouraging to see institutions, such as the Department of Trade and Industry and Competition, moving for the appointments of permanent directors,

reviewing the boards of agencies and looking to deploy appropriate and adequate skills for the various roles therein. We also note the turnaround at Eskom that precedes the GNU, giving us an example of what is possible when the right professionals are given space in the roles they deserve to be in.
South Africa possesses the capacities and professional base to be a thriving economy. For the GNU to be a force for real change, this professional base must be brought into the important work of critiquing the Statement of Intent and developing out of that process, a social compact and real measurables that will enhance the national dialogue, strengthen participatory democracy and unlock socioeconomic justice.
We therefore assume that in the trade-offs that resulted in the formation of the GNU, there would have been the need for this Statement of Intent and, due to the haste with which it may have been developed, it would leave some important gaps. These gaps are the risks to our democracy.
One of those most glaring gaps is that the GNU Statement of Intent is silent on the youth question despite South African youth being exactly those apathetic people who do not vote. It is crucial that the ensuing engagements close these gaps to give real power to the people through the GNU.

President Cyril Ramaphosa in his inaugural speech after being elected as President of South Africa for a second term and head of a government of national unity (GNU) said: “As leaders, as political parties, we are called upon to work in partnership towards a growing economy, better jobs, safer communities and a government that works for its people.” He added: “It is the beginning of a new era.”
These promising words indicate that the GNU prioritises inclusive economic growth, job creation and poverty reduction. However, Black Management Forum (BMF) Young Professionals national deputy chair Ayavuya Madolo warns that if the GNU’s varied interests precede the urgent need for transformative policy changes, this may come at a cost, potentially hampering the country’s transformation goals.
EDWIN NAIDU asks if the government of national unity is geared to deliver inclusive growth
sentiment, resulting in a strong currency, a burning question is whether policies are developed around the nation’s needs or remain aligned with capital and big business, Madolo notes.

In his inaugural speech, Ramaphosa told the nation the GNU will drive inclusive growth and job creation, reduce poverty, tackle the high cost of living, and build a capable, ethical, and developmental state over the next five years. The president promised that his government’s programmes would encourage broad-based black economic empowerment, employment equity and support for small and medium enterprises. These promises were in addition to the October 2020 Project Vulindlela initiative, launched to speed up economic reforms and improve people’s lives by modernising the electricity, water, and transport sectors.
“As the BMF, we just want transformation, socioeconomic transformation; we want to see transformation in the economy. We want to see black people owning and running means of production. We want to see a diverse economy that resembles the country’s demographics,” says Madolo. He adds that transformation imperatives under the GNU can take a backseat, detracting from the nation’s goals if not watched.
While the GNU promises prosperity, jobs and positive international
A recent review shows that at least R500-billion was unlocked through reforms. However, in its 2024 fourth-quarter outlook for South Africa, rating agency Fitch says Vulindlela with 35 priority reforms has had a moderate impact. While the formation of the GNU after the May 2024 general elections lowers short-term policy uncertainty, Fitch says even though the ANC and DA remain broadly aligned on critical priorities, particularly on the growth-enhancing agenda, risks to political stability remain over foreign policy, social grants and the controversial national health insurance and are potentially contentious.
When considering the GNU’s ability to deliver inclusive growth, Madolo
says a key question is whether the policies align with the nation’s needs – a crucial consideration for South Africa’s future. He asks whether state-owned enterprises should be profit-driven when their mission is to serve the people.
Given state-owned enterprises’ poor performance, Madola says public-private partnerships that meet social imperatives are necessary and can help create a better country.
Founder of investment firm Alcon Blue Donavan Pieterse says history offers a strong reminder of the first time a GNU was installed and its disappointing benefits to the country concerning broad-based black economic empowerment (B-BBEE) and employment equity (EE).

“On the surface, the GNU looks rosy, but when the president speaks about things like intensive growth transformation and so forth, one looks at the previous policy regimes – we’ve had affirmative action, B-BBEE without success for the majority, and now we’re talking inclusive growth, but what does that entail?”
Pieterse says transformation policies have benefitted a select few but the majority have been left aside. He says a closer look will reveal that big – and foreign – businesses such as Vulindlela have benefitted more from economic policies and initiatives than the people of South Africa. These are the issues the GNU must focus on if it hopes to deliver inclusive growth.
Black-owned enterprises stand at a pivotal moment, poised to capitalise on emerging sectors that promise robust growth, writes LERATO NAGE, BMF Investment chairperson
The government’s renewed focus on sectors, such as green energy, technology innovation and infrastructure development, provides a fertile ground for these businesses to thrive.
The global shift towards renewable energy presents black-owned businesses with an unprecedented opportunity to lead in South Africa’s green revolution.
The government’s Integrated Resource Plan underscores a commitment to increase renewable energy capacity signi cantly. This policy framework is a gateway for black entrepreneurs to invest in solar, wind and other renewable energy projects.


By aligning their business strategies with government priorities, black-owned enterprises can establish themselves as key players in this burgeoning industry. Moreover, ancillary services, such as technology integration, maintenance and supply chain logistics, within the green energy sector offer additional avenues for growth and innovation.
Technology innovation continues to reshape industries, and South Africa is no exception. With the government’s emphasis on the fourth industrial revolution, black-owned businesses have numerous opportunities to drive technological advancements.
Sectors such as ntech, e-commerce and arti cial intelligence bring opportunities to reduce the startup and operational costs of small and medium enterprises. By leveraging their agility and deep market insights,
black entrepreneurs can develop and deploy cutting-edge solutions that address speci c local challenges. Moreover, the growing demand for cybersecurity services opens a critical niche for black-owned rms to secure digital infrastructures, contributing to the nation’s broader economic resilience.
Infrastructure development remains a cornerstone of South Africa’s economic growth strategy.

The government’s commitment to public-private partnerships and large-scale infrastructure projects offers black-owned businesses signi cant opportunities to contribute to national development. Whether through direct involvement in construction projects, supplying materials or offering project management expertise, these enterprises can play a central role in building the nation’s future.
The focus on urban development and transportation networks also opens possibilities for innovation in smart city technologies and sustainable construction practices, where black-owned businesses can lead the charge.
Other investment opportunities lie in the form of purpose-built student accommodation, which offers immense opportunities and sustainable returns to investors.
The ever-evolving policy environment requires black business leaders to be both adaptable and proactive. The recent
amendments to the Broad-Based Black Economic Empowerment Codes emphasise ownership and skills development, placing renewed pressure on businesses to comply. Staying informed and aligned with these regulatory changes is crucial.
Additionally, black entrepreneurs should actively seek government incentives and funding opportunities, particularly those targeting renewable energy, technology innovation and infrastructure development. These nancial supports can provide the necessary capital to scale operations and drive long-term growth.
The role of black-owned enterprises in emerging sectors is more critical than ever. By strategically positioning themselves within green energy, technology innovation and infrastructure development, these businesses can not only contribute to national growth, but also secure their future in a competitive market. The key lies in understanding the evolving policy landscape, capitalising on government incentives and leveraging the unique strengths black entrepreneurs bring to the table.
The future of black-owned enterprises in South Africa is bright and, with the right strategies, these businesses are well-placed to lead the nation into its next phase of development.
The government has also established Operation Vulindlela (located at the National Treasury), which aims to modernise and transform network industries, including:
• electricity;
• water;
• transport; and
• digital communications. These network industries are the bedrock of economic growth and are essential for creating a globally competitive economy. In addition, reforms to the visa regime are being prioritised to attract skills and promote tourism growth.
The future of black-owned enterprises in South Africa is bright and, with the right strategies, these businesses are well-placed to lead the nation into its next phase of development.
The Economic Regulation of Transport Act may finally shake South Africa’s transport sector out of its stupor, writes TREVOR CRIGHTON
South Africa’s transport industry needed a shake-up – and President Ramaphosa’s assent to the Economic Regulation of Transport Act 6 of 2024 in June is likely to usher in a new era for the sector.
The Economic Regulation of Transport Act 6 of 2024 aims to create a co-ordinated and transparent regulatory framework across all modes of transport, including road, rail, maritime and aviation for both passengers and freight. The creation of the Transport Economic Regulator (TER) is key to this. The TER will consolidate the fragmented regulations governing ports, airports and roads and become the sole price-regulating authority across the broader transport sector.
Byron O’Connor, director at Norton Rose Fulbright South Africa, says the TER will promote efficiency and competition in the sector – and correct the fact that there was previously no economic regulation of rail transport.
Access to South Africa’s rail and port infrastructure is controlled by Transnet, which, in turn, is wholly owned by the South African government. O’Connor says: “The decline in volumes transported by rail has been well documented. Inefficiencies encountered at South Africa’s largest ports have also been reported; these inefficiencies resulted in cargo being diverted to neighbouring countries. The decline in the performance of the freight rail network is attributed to several factors, including underinvestment in the rail infrastructure, a lack of rolling stock availability and security issues relating to theft and vandalism of network infrastructure.”

“What’s key is that the act seeks to ensure that the TER is a skilled and independent (from government) regulatory body. Its board of control will be appointed by the Minister of Transport, pursuant to having received recommendations from an independent panel of experts on governance and public policy,” he explains. “In addition, the act also provides for the establishment of a Transport Economic Council (TEC). The TEC will be responsible for considering complaints by interested parties against regulated entities and appeals or reviews of decisions taken by the TER.”
The rail sector, in particular, requires attention, and O’Connor says that the act can play a role in revitalising it as it allows the private sector to play a role. “Private sector involvement has the capacity to assist with addressing all these issues. In addition, the resultant increase in competition may result in greater responsiveness to customer needs and efficiencies. Much depends, however, on whether the terms of access will be conducive to attracting such private sector participation,” he explains.
“Insofar as privatisation is concerned, the National Rail Policy 2022 white paper outlines a clear policy direction by the government for the rail sector where state ownership of the infrastructure remains but efficiency is improved by the introduction of the private sector.”
Gross domestic product (GDP) from transport in South Africa decreased to R3.8-billion in the second quarter of 2024 from R3.89-billion in the first quarter of 2024. GDP from transport in South Africa averaged R2.7-billion from 1993 until 2024, reaching an all-time high of R3.91-billion in the fourth quarter of 2023 and a record low of R1.2-billion in the first quarter of 1993.
Source: Statistics South Africa
Gavin Kelly, CEO of the Road Freight Association, says the arrival of what he calls the Single Transport Economic Regulator is not about regulating prices within the private sector. “The Single Transport Economic Regulator focuses on the agencies (state-owned enterprises), the statutory costs they place into the economy and, in this case, into the supply chain,” he says.
“Regulating prices within the private sector would be anti-competitive and would be a state monopolisation of the supply chain.” He adds that the new legislation does not alter broad-based black economic empowerment’s role in the sector outside its generic application and that the Department of Trade, Industry and Competition and Sector Charter Councils will continue with their work.

“Regulating prices within the private sector would be anti-competitive and would be a state monopolisation of the supply chain.” – Gavin Kelly


How have the Black Economic Empowerment (BEE) deals, aimed at advancing economic transformation by facilitating broader participation in the country’s economy by black people, conducted conducted before 2008 fared to date?
While many BEE deals have been successful, some have faced challenges due to factors such as high strike prices, poor target company performance and unfavourable economic conditions.
To assess the effectiveness of BEE deals, several key metrics can be used:
• Compound annual growth rate measures the average annual growth rate of a deal over a specific period.
• Grassroots beneficiation evaluates the extent BEE benefits reach marginalised communities and individuals.
• Long-term sustainability assesses the ability of BEE deals to generate sustained economic benefits and avoid short-term gains followed by long-term decline.
South Africa’s economic transformation centred on BEE experienced a significant peak around 2008, coinciding with the last major recession and economic downturn in the country. During this period, many industrial giants entered into bank- or vendor-financed BEE funding transactions.
Companies such as Sasol Inzalo BEE and Media 24-Welkom Yizani have faced challenges, requiring restructuring or extensions. Among those that enjoyed success are Exxaro, Capitec and Sanlam – all of which have demonstrated significant growth and value creation through their BEE initiatives.
The period between 2002 and 2008 witnessed a second wave of BEE deals, driven by Chuma Konyana
strong economic growth and favourable market conditions. MTN is a prominent example of a BEE deal that successfully released significant value for its black investors.
Ideally a black industrialist is a 100 per cent black-owned and black-managed business, where the operational control, cash flows and turnover are led and executed by black business with a turnover north of R1-billion. MTN from 2002 to 2012, to a material extent, reached this pinnacle. It has not been duplicated since.
However, the emergence of black industrialists at scale remains a challenge. Royal Bafokeng is one of the few notable examples, having successfully secured 66 per cent ownership of the Styldrift platinum mine through legal action. It only really entered the BEE fray in the past decade, but a century of right decisions resulted in a title deed for valuable platinum assets, later owned by Anglo Platinum and Impala Platinum.
There has been negligible BEE ownership of the major six banks and top five insurance houses in South Africa, thus the likelihood of economic emancipation and transformation diminishes even further.
While there has never been a scenario of 25.1 per cent unencumbered ownership of a major bank or insurance house, the Sanlam BEE deal, Bantu Botho, has realised substantial value for its broad-based beneficiaries. The Absa BEE deal has also, to a certain extent, achieved this.

The last time the Industrial Development Corporation (IDC) made a significant
In May 2017, the Competition Commission, exercising its powers under Section 43B of the Competition Act No. 89 of 1998, published a notice that it would conduct a market inquiry into the land-based public passenger transport sector. On conclusion of the market inquiry, the Competition Commission wrote:
• National Treasury and the Department of Transport must establish a funding scheme for black bus operators.
• Thirty per cent of new subsidy contracts must be awarded to black bus operators.
• New subsidy contracts must be broken into smaller pieces to accommodate small business owners.
• The subsidy policy for negotiated commuter subsidy, the Integrated Public transport Network and the Bus Rapid Transport must be finalised. These recommendations have not been actioned or finalised.
foray into the financial services industry was in 2006–2009, when it funded and disbursed the Capitec Bank BEE, Real People BEE and Alexander Forbes BEE ventures.
The Sasfin Bank BEE, African Dawn BEE and MEEG Bank deals were approved but not disbursed. During this period, the IDC extended R200-million each to the Development Bank of Zambia and the Swazi Development Bank.
The IDC also extended R200-million to the IDC/Scania JV (asset finance) venture to black bus operators, terminated by Scania Finance prematurely after disbursing R80-million in the first six months. Only now, in September 2024, has the IDC emulated the same funding scenario and disbursed R200-million to the Development Bank of Namibia.
BUSANI MOYO chats with Professor Wiseman Nkuhlu about the state of African regional integration and learns how it has taken a backseat in the recent past
Even though shared values and cultural similarities across African nations can provide black businesses with relational advantage, doing business across Africa still presents challenges due to the continent’s diverse political, economic and regulatory environments.

Shared values such as Ubuntu – which stress the importance of co-operation, trust and community –can nurture robust relationships, partnerships and trust among African entrepreneurs.
On this basis, the idea that South African black businesses can benefit from improved African integration is supported.
With a new government of national unity (GNU) in place, a new question arises: What will its approach to regional integration be, and how will it open up opportunities for black-owned businesses in South Africa to expand into other African markets? This is the question we posed to the chairman of KPMG South Africa, Professor Wiseman Nkuhlu.
Asked whether we know yet whether the GNU has an approach to African integration, Professor Nkuhlu admitted: “I don’t know the policies of the government of national unity.” He added that there is no clarity yet about “how the policies of the ANC are going to be linked with those of other partners in the GNU”. With 10 parties in the GNU, this is indeed an important question.
“My view is that regional integration is in the interest of business and therefore I would expect the pro-business parties in the GNU to support regional integration.” – Professor Wiseman Nkhulu
If Professor Nkuhlu doesn’t know the GNU’s policies concerning regional integration, he knows a lot about why integration is important. After all, he served as the chief executive of the Secretariat of the New Partnership for Africa’s Development (NEPAD) from 2000 to 2005. “My view is that regional integration is in the interest of business and therefore I would expect the pro-business parties in the GNU to support regional integration.”
If there is no clarity about the new government’s approach to regional integration, the good news is that prior South African governments took regional integration seriously. Professor Nkuhlu agrees: “In the early 2000s, South Africa had a clear policy and programme for regional integration.” He says that at this time, the government encouraged businesses, “even parastatals, such as Eskom, to work with their counterparts in other countries”.
These efforts, he says, were co-ordinated through a NEPAD business forum in which prominent businessman Dr Reuel Khoza played a massive role in establishing. That forum aimed to facilitate investment by South African companies in other parts of the continent, working very closely with the government.
Professor Nkuhlu posits that the efforts in the early 2000s, which saw the establishment of the NEPAD
business forum with government support, indicate that while the government has supported African integration up to about 2015, “political leadership may not have been strong in the recent past”.
Are we likely to see regional integration improve under the GNU? “In the short term, the GNU is likely to cause uncertainty, but we hope, over time, it will clarify its position,” Professor Nkuhlu comments. He suggests that this means business is currently in a state where it is posing and waiting to see how the new government will address the issues around integration that concern business today.
Asked what an effective African integration strategy would look like, Professor Nkuhlu says the focus should be on easing movement within the continent, particularly of qualified people. He notes that “there have been some concerns that we are not as accommodating as we should be in terms of facilitating the movement of professionals and business leaders into South Africa”.
Professor Nkuhlu suggests that proper integration means sorting out the basics, such as issuing visas more efficiently and creating the right chemistry between the leaders of African countries.
He argues that there will be investment benefits if the chemistry between leaders of different African countries is good.


On 6 June, the BMF, in collaboration with Henley Business School, hosted the thought-provoking “Beyond the Ballot” event at Henley’s Cape Town campus. This gathering, attended by a diverse mix of business leaders, professionals and thought leaders, focused on addressing South Africa’s post-election sociopolitical landscape. It provided an engaging platform for attendees to gain insights from an esteemed panel. The in-person audience was joined online by the highly respected Professor Thuli Madonsela, who shared invaluable perspectives on constitutional democracy and governance, alongside other prominent panellists.
The “Beyond the Ballot” event not only sparked crucial discussions about South Africa’s political and economic future, but also reaffirmed the vital role of ethical leadership and governance in shaping the country’s trajectory. As businesses and leaders navigate a complex post-election landscape, the insights from the panel and other esteemed contributors from the audience provide a roadmap for fostering a more inclusive and accountable society.


The 2024 Women’s Month event, held at Henley Business School in partnership with Old Mutual, was a resounding success. The theme, “Celebrating the Journey of Women in Leadership –30 Years On,” brought together a diverse group of South African women, business leaders and rising stars for an evening of inspiration and empowerment.
The event’s centrepiece was a thought-provoking panel discussion featuring some of the country’s most influential female leaders. Busisiwe Mavuso, CEO of Business Leadership South Africa, Sindi Mabaso-Koyana, co-founder of the African Women Chartered Accountants Association, and Celiwe Ross, director of group strategy sustainability at Old Mutual, shared their insights on the challenges, triumphs and evolving role of women in leadership over the past three decades. The panel delved into the complexities of navigating male-dominated industries, the importance of policy reform and explored the progress made and what still needs to be done to create a more equitable and inclusive business landscape.

The BMF hosted the ninth Annual Don Mkhwanazi Lecture, celebrating the enduring legacy of one of South Africa’s most influential leaders in business and socioeconomic empowerment, “Bra Don”. Keynote speaker Tembakazi Mnyaka, former deputy president of the BMF, delivered an inspiring address on Don Mkhwanazi’s lasting influence on black business and economic transformation. Thobile Mkhwanazi, Don Mkhwanazi’s daughter, shared a heartfelt reflection on her father’s enduring legacy, personally and professionally.

THE BMF, in partnership with the Maduke Lot Ndlovu Trust, proudly marked the return of the annual Lot Ndlovu Memorial Golf Day on 27 August at the prestigious Bryanston Country Club. This much-anticipated event brought together professionals, business leaders and corporate partners to honour the legacy of Dr Lot Ndlovu.
On 4 September, the BMF and Henley Business School Africa unveiled a landmark partnership poised to cultivate a new generation of leaders adept at steering South Africa towards economic and social transformation. This alliance is strategically designed to arm future executives with the necessary skills, knowledge and
thriving society.
With 62 enthusiastic golfers participating in 12 fourballs, the event was well-supported by key sponsors, such as Santam, Nedbank and Old Mutual. The Memorial Golf Day is a platform to continue Dr Ndlovu’s mission of uplifting disadvantaged communities. Funds raised from the event will support educational initiatives by the Maduke Lot Ndlovu Trust, ensuring Dr Ndlovu’s vision for an inclusive and empowered South Africa continues to thrive.

